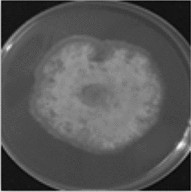
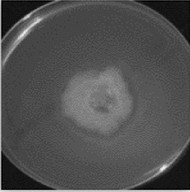

Table 2 Colony diameter of B. cinerea under different treatments
Time (h) | Colony diameter (mm) | |||
|---|---|---|---|---|
CK | T1 | T2 | T3 | |
24 | 25.78 ± 0.45a | 22.48 ± 0.40b | 22.95 ± 0.35b | 25.48 ± 0.46a |
48 | 38.04 ± 0.27a | 27.65 ± 0.61c | 29.63 ± 0.68b | 37.91 ± 0.62a |
72 | 49.27 ± 0.24a | 35.78 ± 0.49d | 40.29 ± 0.56c | 47.30 ± 0.41b |
Photo (72 h) |
|
|
|
|